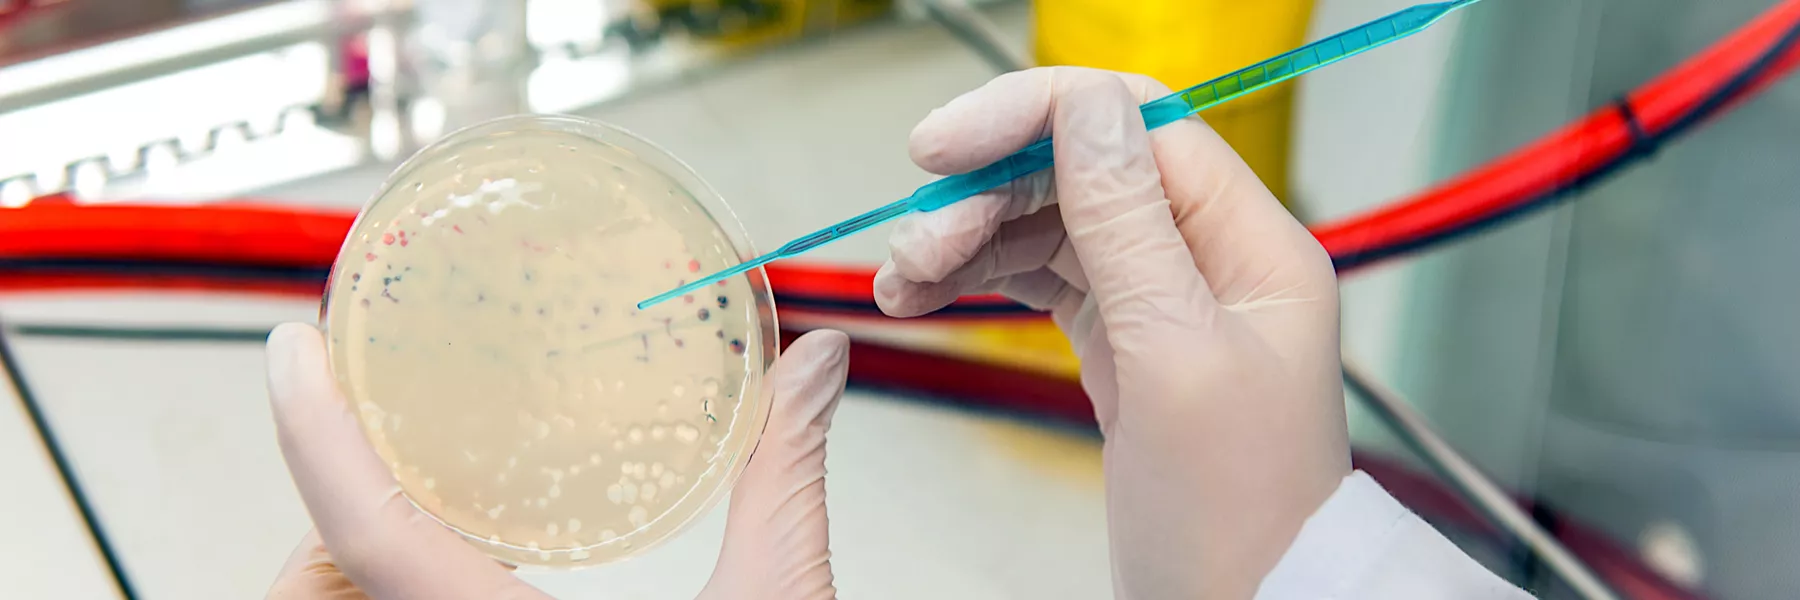

The overall cleanliness of polypropylene (PP) articles for food preparation has long been a concern in both commercial and domestic areas.
The propensity for microorganisms and sustaining nutrients to collect in the surface abrasions over time continues to challenge all but the most persistent cleaning practices.
As such, antimicrobial incorporation within the material is another technological advancement that can be very effective as an adjunct to regular sanitization. However, to be practical, the antimicrobial effect must also be durable, and able to withstand the routine cleanings that are fundamental to food preparation hygiene.
To demonstrate the antimicrobial longevity of Microban silver-based antimicrobial treatments in PP articles, Microban engineers have conducted an assessment of the durability of the treatment over prolonged periods of use. This paper will describe the work done and provide data supporting the success in achieving this primary design requirement. The results will show that:
- Injection-molded samples with the Microban silver-based treatment will, under conditions of normal use, demonstrate antimicrobial efficacy after 75 mechanical dishwashing cycles plus at least 336 hours of additional hot water cleaning (i.e. over 4000 manual washing of 5 minutes).
- As the sample is abraded over time due to cuts, scoures, and cuffs associated with repeated use and scouring, the efficacy is renewed, thereby prolonging the benefits of the treatment over the useful life of the product.
The Wash Durability Evaluation Process
The extent of product longevity was undefined, so the most practical way to determine when the surfaces lost their antimicrobial effect was to repeatedly wash them, then measure the efficacy using an industry-standard test method. In this way continuous patterns of usage could be established, simulating prolonged periods of wear. Accordingly, a set of samples of the polypropylene plaque containing the Microban silver treatment and an identical set of samples without the treatment were exposed to 75 domestic dishwasher cycles. The temperature settings for these were 50°C for washing and 60°C for rinsing.
Initially, washes were conducted with a brand name dishwasher detergent in every cycle. However, since it was discovered that the buildup of the detergent on the untreated samples resulted in positive efficacy measurements, detergent use was reduced to four consecutive cycles with it, followed by one without so that only the effect of the silver treatment could be measured.
After a total of 75 cycles, the three samples each from the treated and untreated sets were tested for efficacy versus Escherichia coli (E. coli) using the method given in the ISO standard 22196 for the measurement of antibacterial activity on plastics and other non-porous surfaces. The inoculum applied to each sample contained 190,000 colony forming units (CFU) of the organism. The results are given in TABLE 1.
TABLE 1: Antimicrobial Activity of Silver Treated Polypropylene After 75 Dishwasher Cycles
Sample from Dishwasher Cycles |
Surviving E. coli (CFU) |
Average Percent (Log) Reduction vs. Untreated Polypropylene |
Microban Silver Treated Polypropylene - Replicate 1 |
< 100 |
99.9% (3.8) |
Microban Silver Treated Polypropylene - Replicate 2 |
56,000 |
|
Microban Silver Treated Polypropylene - Replicate 3 |
< 100 |
|
Untreated Polypropylene - Replicate 1 |
> 4,900,000 |
|
Untreated Polypropylene -Replicate 2 |
> 4,900,000 |
|
Untreated Polypropylene -Replicate 3 |
> 4,900,000 |
It can be seen readily that the E. coli was able to thrive on the washed, untreated samples while those with the silver treatment were efficacious in reducing the bacterial population by at least 99.9% on average. Given this strong performance, it was decided to extend the washing simulations further to determine the limits of the treatment durability.
In order to accelerate the exposure process, a scheme for simulating additional washing was devised wherein the previously machine-washed samples, treated and untreated, were immersed in a circulating water bath at a controlled temperature of 80°C (176 F). After continuous exposures of 168 hours (7 days) and 336 hours (14 days), 3 samples from each set were again taken and submitted for antibacterial efficacy testing using the same methodology with similar inoculation levels. TABLE 2 summarizes the outcomes of this work.
TABLE 2: Antimicrobial Activity of Silver Treated Polypropylene After 75 Dishwasher Cycles Plus Additional Continuous Exposures to Hot, Recirculating Water
Sample from 75 Dishwasher Cycles Plus Additional Exposure |
Addition Exposure Days |
Surviving E. coli (CFU) |
Average Percent (Log) Reduction vs. Untreated PP |
Microban Silver Treated PP - Replicate 1 |
7 |
< 100 |
99.9% (3.7) |
Microban Silver Treated PP - Replicate 2 |
7 |
< 100 |
|
Microban Silver Treated PP - Replicate 3 |
7 |
95,000 |
|
Untreated PP - Replicate 1 |
7 |
> 4,900,000 |
|
Untreated PP - Replicate 2 |
7 |
> 4,900,000 |
|
Untreated PP - Replicate 3 |
7 |
> 4,900,000 |
|
Microban Silver Treated PP - Replicate 1 |
14 |
600,000 |
99% (1.9) |
Microban Silver Treated PP - Replicate 2 |
14 |
600 |
|
Microban Silver Treated PP - Replicate 3 |
14 |
600,000 |
|
Untreated PP - Replicate 1 |
14 |
> 4,900,000 |
|
Untreated PP - Replicate 2 |
14 |
> 4,900,000 |
|
Untreated PP - Replicate 3 |
14 |
> 4,900,000 |
Again, significant reductions in the test organism were measured on the treated samples when compared to the untreated up to 75 dishwasher cycles plus 14 days continuous exposure to hot, running water. Yet, an equally significant difference in efficacy is apparent between the treated samples with 14 days (1.9 log average reduction) additional exposure versus those with only 7 days (3.7 log average reduction). This indicates that continued exposures will result in conditions where the samples show no significant efficacy.
On the other hand, it needs to be considered that under real-world conditions, most articles are not only exposed to copious amounts of hot water as they age, but also undergo noticeable surface abrasion caused by scoring from utensils and scuffing from various materials. When this occurs, the benefit of the additive being incorporated into the construction material rather than topically applied comes into play. Unlike topical applications, antimicrobial treatments built into the polymer matrix are renewed as new surfaces are exposed by wear. Samples from this group that demonstrated poor efficacy after extensive wash exposures provided a perfect opportunity to demonstrate this effect.
Surface Wear and Antimicrobial Efficacy Regeneration
In order to eliminate the efficacy of the treated samples, the water exposure was continued on the remaining samples for an additional 21 days (i.e., a cumulative 35-day exposure). At this point, the treated and untreated samples were tested for efficacy again. TABLE 3 shows that efficacy depletion was finally achieved since reductions below 1.0 log are not considered significant by microbiologists.
TABLE 3: Antimicrobial Activity of Silver Treated Polypropylene After 75 Dishwasher Cycles Plus 35 days Cumulative, Continuous Exposures to Hot, Recirculating Water
Sample |
Surviving E. coli (CFU) |
Average Percent (Log) Reduction vs. Untreated Polypropylene |
Microban Silver Treated PP - Replicate 1 |
3,000,000 |
21% (0.1) |
Microban Silver Treated PP - Replicate 2 |
> 4,900,000 |
|
Microban Silver Treated PP - Replicate 3 |
> 4,900,000 |
|
Untreated PP - Replicate 1 |
> 4,900,000 |
|
Untreated PP - Replicate 2 |
> 4,900,000 |
|
Untreated PP - Replicate 3 |
> 4,900,000 |
Surface Wear Simulation
Scoring Simulation
Test samples at the efficacy failure point were scored with 25-30 cuts per inch applied in two directions perpendicular to each other on the sample surfaces. See ILLUSTRATION below.

Scuffing Simulation
A separate wear application was done with a scouring pad, which simulated manual washing or any surface scrubbing processes.
Both of these stressed surfaces were then submitted for antimicrobial efficacy testing as previously described. The efficacy values for these samples are summarized in TABLE 4.
TABLE 4: Antimicrobial Activity of Silver Treated Polypropylene After 75 Dishwasher Cycles Plus 35 Days of Additional Continuous Exposures to Hot, Recirculating Water AFTER SURFACE STRESSING
Washed Sample with Surface Stresses |
Surface Stress |
Surviving E. coli (CFU) |
Average Percent (Log) Reduction vs. Untreated Polypropylene |
Microban Silver Treated PP - Replicate 1 |
Knife Cuts |
100,000 |
99.9% (2.9) |
Microban Silver Treated PP - Replicate 2 |
Knife Cuts |
< 100 |
|
Microban Silver Treated PP - Replicate 3 |
Knife Cuts |
30,000 |
|
Microban Silver Treated PP - Replicate 1 |
Scouring Scuffs |
< 100 |
99.8% (2.7) |
Microban Silver Treated PP - Replicate 2 |
Scouring Scuffs |
71,000 |
|
Microban Silver Treated PP - Replicate 3 |
Scouring Scuffs |
170,000 |
|
Untreated PP - Replicate 1 |
Unstressed |
> 4,900,000 |
N/A |
Untreated PP - Replicate 2 |
Unstressed |
> 4,900,000 |
|
Untreated PP - Replicate 3 |
Unstressed |
> 4,900,000 |
These results indicate that the act of stressing the surface in ways that are part of normal use is sufficient to renew the antimicrobial activity of the product. This also demonstrates the benefit of having Microban antimicrobial additive build into the material over surface treatment in such applications. Consequently, there is every reason to expect that the efficacy will be persistent as the product is abraded and cleaned over the course of its useful lifetime.
Conclusion
The work reported here shows that the designed antimicrobial effect can be expected to endure 75 mechanical dishwasher cycles plus 336 hours of manual soaking and washing with hot water. The amount of manual exposure can be translated into over 4000 handwashing cycles of 5 minutes each. This performance is measured solely on the original, unaltered surface of the PP plaques.
As the number of washes the sample undergoes increases, the efficacy can be seen to slowly decrease, but this does not take into account surface wear that accompanies use over the same period. This wear has been shown to renew the efficacy by exposing the built-in additive to the surface. Thus it is reasonable to expect that, unlike topically applied antimicrobials, the Microban silver-based treatment in the articles will endure over the useful life of the product.
Written by the Materials Engineering Group, Research and Development, Microban Products Company
Mai Ha, Ph.D., Senior Product Development Engineer
Burke Nelson, Ph.D., Director of Materials Engineering
Duane Centola, Director of Project Management